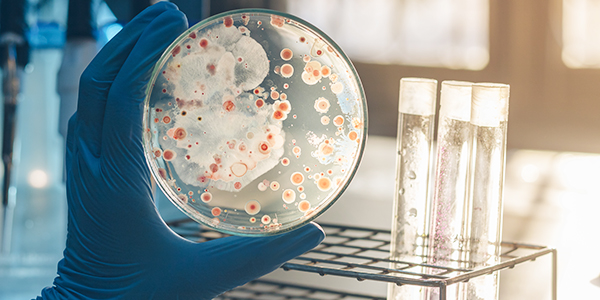
bioremediation

Jerry Seinfeld said, “Did you ever get something on your clothes and brush it off with your hands? That’s dry cleaning.” While Jerry’s dry-cleaning routine is funny, it's not factually accurate, and those affected by the residual chemicals used in "dry" cleaning tend not to...
Posted at 11:00h
in
Commentary,
Environment
Forest fires are in the news. Again. Currently, several fires are burning out west. Climate change is blamed for the widespread droughts and, subsequently, for the increase in the frequency of forest fires. It seems, however, that the cause of forest fires is often misunderstood....
To the casual observer, environmental remediation appears to be highly physical and destructive work. In industrial and commercial (and even residential) areas of metropolitan New York and New Jersey, it's not uncommon to see remediation work zones with bulldozers, dump trucks, excavators, and drill operators...
Hold on tight, because ESA's David Fullmer is about to throw down some super serious (and super interesting) science in this next article on natural solutions to unnatural environmental problems. Specifically, we're talking about how to get rid of nasty chlorinated solvents using an unlikely...
Readers of ESA’s articles know that our goal is to lessen the amount and degree of environmental services needed to effect compliance. Our recent three-part series addressing soil, groundwater, and PFAS remediation highlights ESA’s commitment to that objective. In some cases, however, contaminant concentrations are...
The NJDEP continues to evaluate the potential human health and environmental impacts of a variety chemicals they have designated as emerging contaminants. The class of chemicals known as Per- and polyfluoroalkyl substances, referred to as PFAS, are NJDEP’s primary concern. In March 2019, NJDEP adopted...
The odds are excellent that you have hazardous materials in your home. Everyone does. And it is likely that you never thought much about it. As defined in Part 1 of this series, hazardous substances do not become a hazardous waste until the user/generator declares...
ESA Environmental Consultants is one of more than 200 environmental consulting companies working in New Jersey. Collectively, these consultants address thousands of contaminated sites at any one time. Perhaps more impressive is the fact that well over 20,000 impacted properties have been remediated in New...
When people read or hear about incidents involving hazardous waste, it often leads to feelings of fear and confusion. Part of the confusion comes from the fact that most individuals don't know what the words "hazardous waste" "hazardous material" and "toxic substance" really mean (hint...
Environmental sustainability is defined as interacting responsibly with our planet to preserve natural resources, support environmental quality, and ensure that future generations are able to maintain an acceptable quality of life -- especially when it comes to access to clean water and clean food. To...
Ask our expert environmental consultants for help solving your environmental challenges.